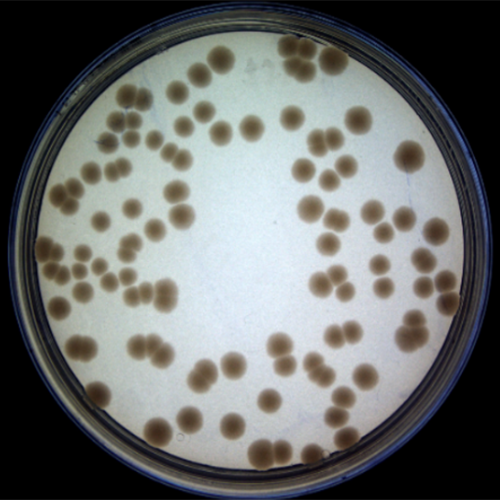
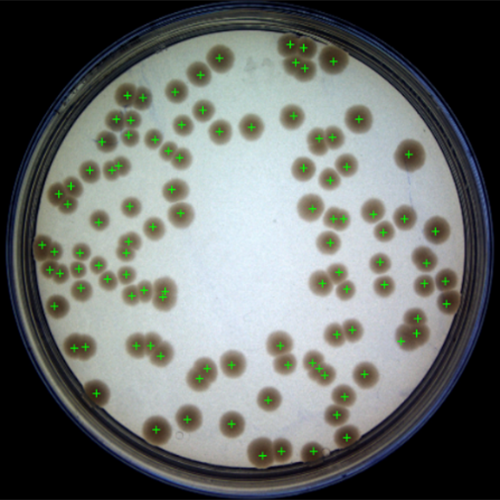
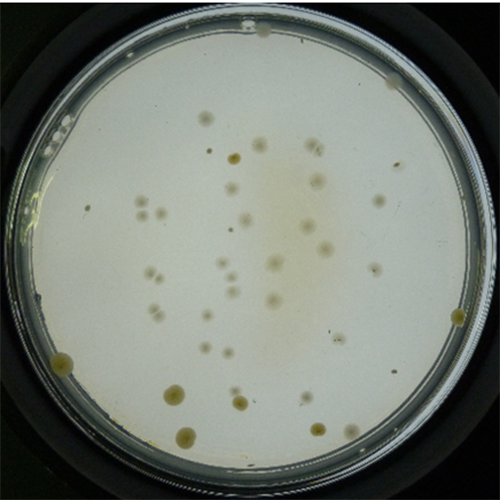
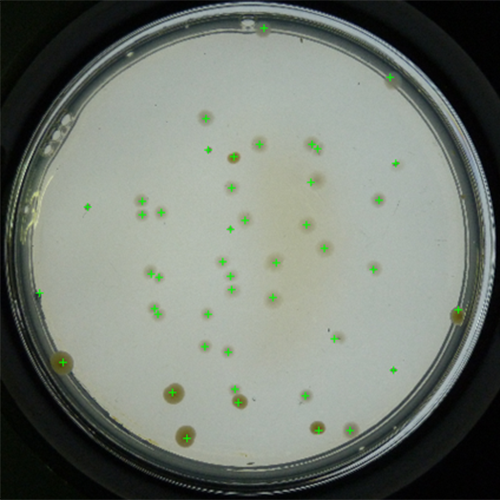
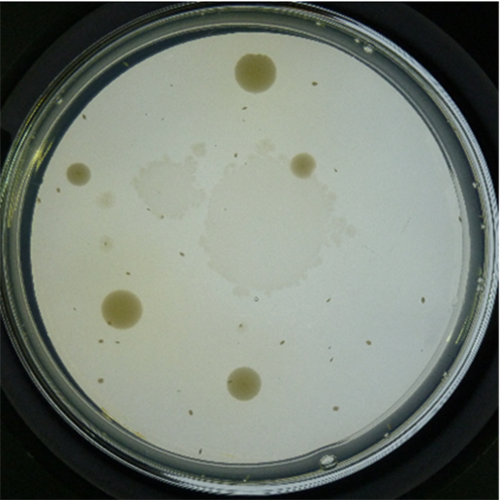
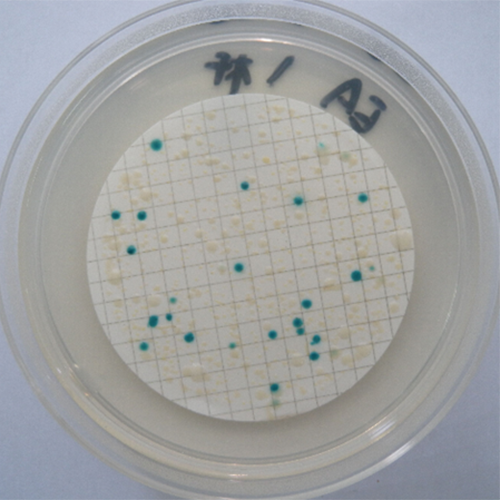
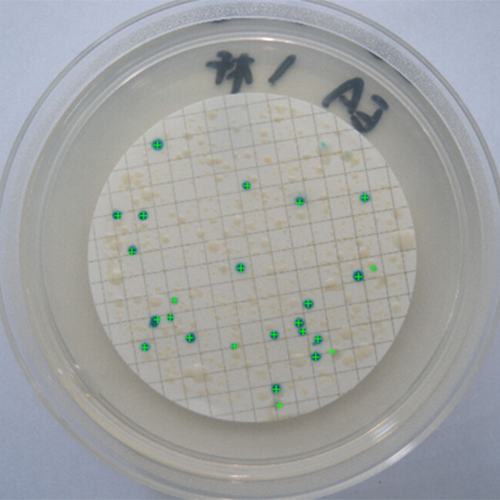
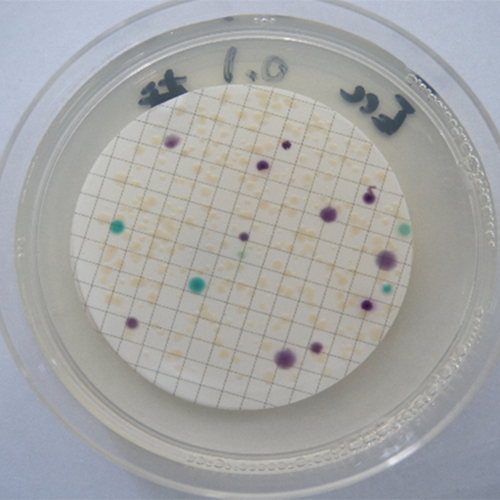
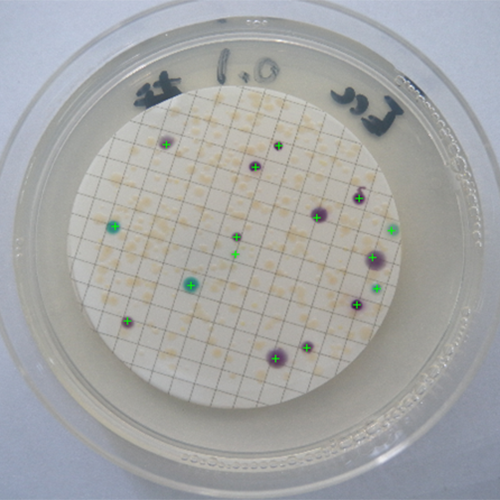
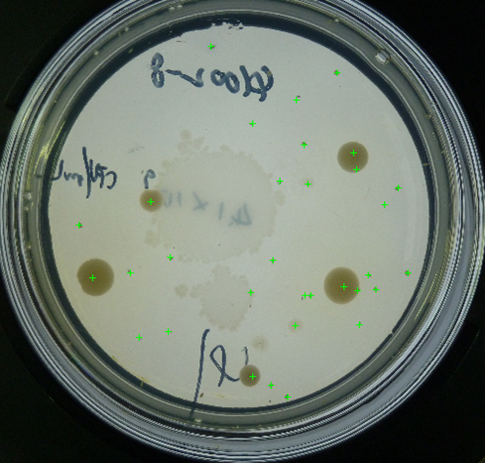
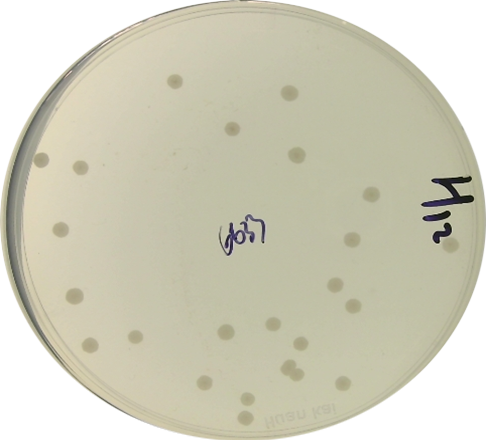
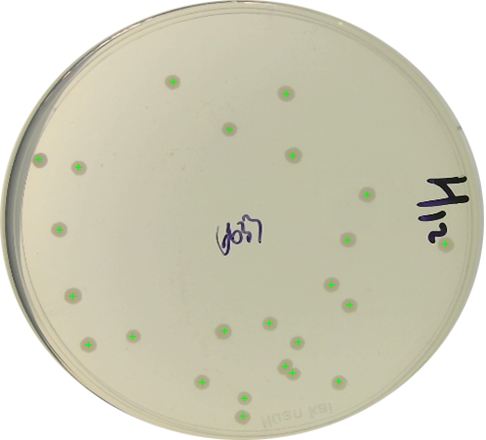
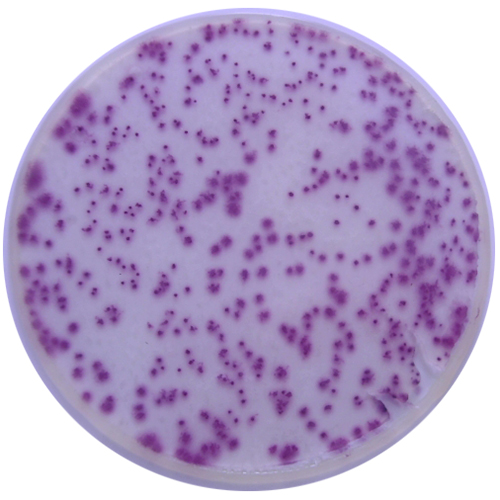
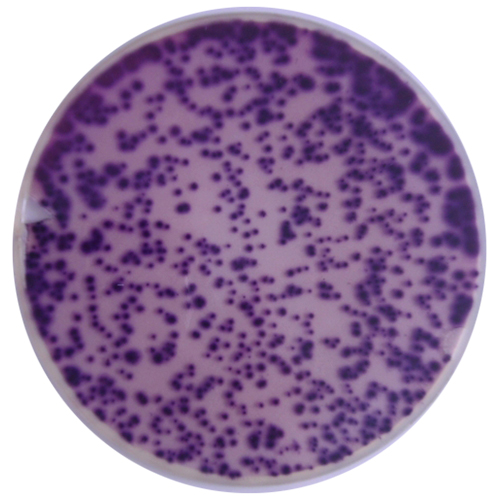
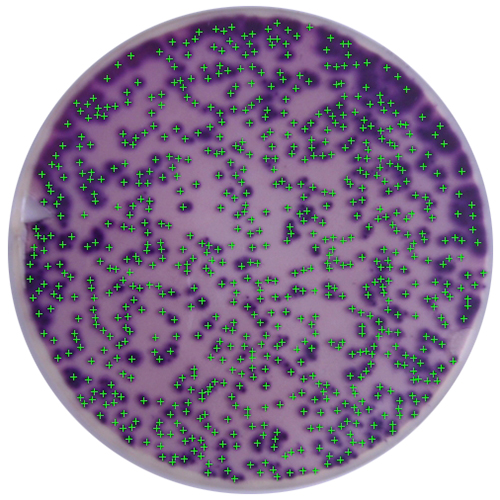

新一代Smartcounter全自动菌落计数器
发布时间:2021-04-01 浏览次数:11491 分享:
目前市面上已有的菌落计数器大多存在溯源困难,识别精度低,统计速度慢,抗干扰能力弱,参数调节难,特异性菌落识别困难等问题。为了避免这些问题,操作人员在使用时必须经历三个过程(前处理,参数设置,后处理)。
在前处理过程中,操作人员需要用酒精溶液擦除平皿上的笔迹,然后用吸水纸清除平皿内外的水珠,最后才能用于识别。在识别之前需要人工调整光源,光源采用白色光源,只有开/关两种可调模式。这影响了对特异性菌落的拍摄效果和图像质量,不能满足识别要求,使得最终识别效果较差甚至完全不能识别。鉴于此,环凯自主研发的Smartcounter全自动菌落计数器通过采用先进的图像采集技术从源头保证了图像采集的质量,开发了“抗笔迹干扰”功能,有效避免了笔迹对识别造成的影响。此外增加了无级调光和无级补光功能,您只需用鼠标做几步简单的操作即可调整光的颜色和明暗,并可以在界面上实时观看成像质量,使拍摄效果达到最佳,完成对特异性菌落的识别的前处理操作。
在参数设置过程中,市面上已有的菌落计数器采用的是“黑箱”操作。在识别之前,您需要设置一系列的参数,并且在设置这些参数的过程中您完全无法知道这些参数对最终识别结果的影响。在参数设置完成后,您需要点击识别按钮,计算完成后才能查看最终识别效果。若识别效果不佳,您可以重复上述步骤直至识别效果可接受为止。整个过程繁琐费时,并且一些参数涉及到图像处理和智能算法相关知识,上手困难,易用性不佳。为此,环凯Smartcounter全自动菌落计数器软件采用交互式设计,你只需拖拉鼠标或滚动滚轮即可调整参数,可以在图像窗口实时查看当前参数对最终识别效果的影响。软件采用全新的智能算法,大大的减少了需要调节的参数个数,提高了软件的易用性。
在后处理过程中,通常需要针对识别结果做适当微调,如手动添加和删除识别结果等。市面上大多采用的是“划出”区域的方式,具体做法是先选择某种形状,如长方形或圆形然后在图像上划出对应形状的区域,区域内部即不统计区域或错误区域,这种做法不是非常便捷。环凯Smartcounter全自动菌落计数器软件采用全新的识别技术保证了较高的识别准确度,大部分情况下不需要做进一步后处理。为进一步提高最终识别结果准确度,软件开发了“人工辅助识别”模块,采用“点选”的方式,您只需点击鼠标左右键直接对识别结果操作,方式更直观,效率更高。
此外,环凯Smartcounter全自动菌落计数器开发有市面上的大部分菌落计数器不具有的功能,如三级权限管理,审计追踪,结果溯源,相机像素调节等功能。软件采用登陆的模式,设有三级权限,根据登陆的权限开放对应的功能,保证了数据的安全性。同时数据采用加密处理,进一步保证了数据的安全性。审计追踪功能可以让您随时了解仪器使用历史情况,掌握仪器的动态。结果溯源功能可以让您检索历史识别结果,和批量导出。像素调节功能可以让你根据需要随时调节拍摄像素。
Smartcounter全自动菌落计数器性能稳定、功能强大、使用操作界面简单直观。具有对微生物菌落进行统计、分析、测量、数据存贮和管理、分析结果报表打印等全系列先进的功能,是微生物实验室的理想设备。
软件主界面及功能简介
软件界面简洁直观,全部操作皆能通过简单易懂的窗口式界面单击鼠标即可完成。

产品特点
1、采用4K真彩色高分辨率摄像装置及超低畸变光学镜头,在硬件上保证拍摄的图像达到极高的清晰度,使得实验数据结果的准确可靠。
2、采用开放式平台设计,取、放培养皿的操作更方便、快捷。
3、底部及上部均设有独立梯度亮度可控的360°LED双光源设计,底部光源采用专利多彩下沉光源设计,光线均匀性更佳,多重光源协同,避免外界光线对开放平台上的菌落影像干扰。
4、Smartcounter用户操作界面友好、简洁、易用,实验人员可以快速上手、掌握平皿菌落计数操作。
5、通过Smartcounter菌落智能识别技术,专业的图像处理算法能快速统计不同接种方式的平皿菌落数,1~5秒内即可完成一个常规平皿的菌落计数,节省大量的人力和时间,极大地提高微生物检测人员的工作效率。
6、粘连菌落分割:Smartcounter菌落智能识别技术能够自动分割粘连的菌落。
7、仪器三级权限管理,充分、有效保障软件的管理和应用安全。
8、自动保存菌落统计结果及对应菌落图片,符合各种标准的溯源要求:可按需求保存检测统计结果,保存的统计数据将自动处理并储存对应的培养皿菌落图像,为监督检测提供有效的法律依据。
9、多色统计:采用智能算法,自动统计菌落颜色;
10、全自动智能工作与人手协调配合:软件自动统计后,可人工添加、删除软件错误判断的菌落,对统计结果进行修正,实现100%的统计准确率。
11、统计区域可选择:可通过鼠标和滚轮改变识别区域,操作方便快捷。
12、权限管理功能:三级权限模式,根据登陆权限开启对应的功能,数据更安全;
14、账户管理功能:高权限用户可以删除、添加低权限账户。
15、格栅膜上菌落计数:软件可以识别格栅膜上的菌落,识别精度高,稳定性好;
16、抗笔迹干扰:软件可以在一定程度上消除培养皿上的笔迹对识别效果的影响。
17、参数调节:采用交互式参数调节模式,调节过程更直观、便捷;
18、光源调节:用户可以通过软件对光源的位置和颜色调节(部分型号),增强对不同培养基或特异菌落的识别能力;
19、结果输出:用户可以以.xls和.pdf的格式输出或批量输出统计结果;
识别效果展示
软件采用了先进的智能算法,在保证了识别精度的同时兼顾了识别速度,您只需用鼠标做少量的操作即可在3-5s时间内即可完成300CFU以上的菌落识别,误差不超过0.6%。
普通菌落+粘连菌落

明暗差异较大的菌落
![]() | ![]() |
直径差异较大的菌落
![]() | ![]() |
格栅膜上特异颜色菌落的统计
![]() | ![]() |
需要多色统计的菌落
![]() | ![]() |
带有笔迹干扰的菌落
![]() | ![]() |
带有笔迹干扰的菌落
![]() | ![]() |
HANDY PLATE菌落识别: 纸片计数在菌落计数器上的应用实例
![]() | ![]() |
| 菌落计数器计数前 | 菌落计数器计数效果 |
![]() | ![]() |
| 菌落计数器计数前 | 菌落计数器计数效果 |